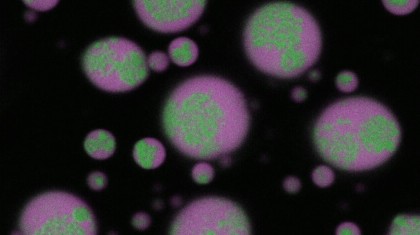
O descoperire majoră: Cum pot fi prevenite și dizolvate aglomerările de ARN din celulele cerebrale

O descoperire majoră: Cum pot fi prevenite și dizolvate aglomerările de ARN din celulele cerebrale
Autor: Airinei Camelia
Un studiu recent publicat în revista Nature Chemistry de cercetătorii de la University at Buffalo a identificat un mecanism cheie prin care agregatele solide de ARN implicate în boli neurologice pot fi atât prevenite, cât și dizolvate. Această descoperire oferă o nouă cale terapeutică pentru afecțiuni precum boala Huntington și scleroza laterală amiotrofică.
În bolile neurodegenerative, agregatele solide de ARN din celule acționează ca bureți moleculari, sechestrând proteine esențiale pentru funcționarea neuronală. Aceste conglomerate de ARN repetitiv, considerate anterior ireversibile, sunt o caracteristică recurentă în celulele afectate de patologii precum ALS sau Huntington. Mecanismul exact al formării acestor structuri era, până recent, necunoscut.
Mecanismul de formare al agregatelor de ARN
Studiul a demonstrat că formarea acestor agregate este facilitată de condensatele biomoleculare, structuri lichide intracelulare formate din proteine și acizi nucleici. Aceste condensate oferă un mediu propice pentru desfășurarea moleculelor de ARN repetitiv și pentru agregarea lor într-un nucleu solid ARN-rich, înconjurat de o zonă fluidă ARN-deficitară.
Interesant este faptul că aceste nuclee solide persistă chiar și după ce condensatul gazdă dispare, ceea ce explică de ce agregatele de ARN au fost considerate greu de eliminat.
Strategii pentru prevenirea și dizolvarea agregatelor
Prevenirea cu ajutorul proteinei G3BP1
Prima strategie propusă de echipă implică folosirea proteinei G3BP1, cunoscută pentru capacitatea sa de a se lega de ARN. Introducerea acesteia în condensate inhibă formarea agregatelor prin perturbarea interacțiunilor dintre moleculele de ARN. Practic, G3BP1 acționează ca un chaperon molecular, care previne lipirea între moleculele de ARN.
Dizolvarea cu oligonucleotide antisens (ASO)
Pentru dezagregarea structurilor deja formate, cercetătorii au utilizat oligonucleotide antisens (ASO) - molecule scurte de ARN proiectate să aibă o secvență complementară ARN-ului repetitiv. Acestea nu doar că se leagă de ARN-ul agregat, dar reuşesc să disloce structura solidă, restabilind un mediu celular sănătos.
Importanța secvenței exacte a ASO-ului este crucială: orice modificare a acesteia anulează capacitatea de dizolvare. Acest fapt susține viabilitatea utilizării ASO-urilor ca terapie de precizie pentru boli asociate cu ARN repetitiv.
Relevanță evolutivă și biotehnologică
Cercetătorul principal, dr. Priya Banerjee, explorează și rolul ARN-ului în originile vieții. Condensatele biomoleculare ar putea fi fost esențiale în protejarea funcțiilor catalitice ale ARN-ului în condițiile dure ale Pământului primitiv.
Descoperirea subliniază faptul că ARN-ul poate adopta forme materiale diverse, unele benefice pentru funcționarea biologică și altele patogene, ceea ce deschide noi direcții în cercetarea bolilor și în biologia sintetică.
Concluzii
Acest studiu oferă dovezi clare despre mecanismele fizico-chimice ale agregatelor de ARN și introduce soluții funcționale pentru prevenirea și dizolvarea acestora. Combinația dintre înțelegerea fundamentală a condensatelor și intervenția moleculară precisă prin ASO oferă perspective promițătoare pentru dezvoltarea de terapii inovatoare pentru boli neurodegenerative.
Foto: Grupările de ARN (cu verde) se dezasamblează treptat în condensatele biomoleculare (cu magenta), readucând ARN-ul la o stare solubilă. University at Buffalo
Copyright ROmedic: Articolul se află sub protecția drepturilor de autor. Reproducerea, chiar și parțială, este interzisă!
- Implant silicon sani
- Pentru cei cu anxietate si atacuri de panica FOARTE IMPORTANT
- GRUP SUPORT PENTRU TOC 2014
- Histerectomie totala cu anexectomie bilaterala
- Grup de suport pentru TOC-CAP 15
- Roaccutane - pro sau contra
- Care este starea dupa operatie de tiroida?
- Helicobacter pylori
- Medicamente antidepresive?
- Capsula de slabit - mit, realitate sau experiente pe oameni